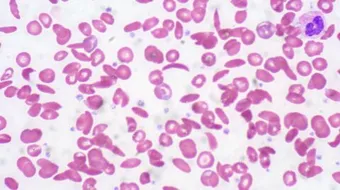
أعراض نقص كريات الدم البيضاء عند الرجال

أعراض نقص كريات الدم البيضاء عند الرجال
أعراض نقص كريات الدم البيضاء عند الرجالتوجد في الدم عدة أنواع من الخلايا، منها خلايا الدم البيضاء (بالإنجليزية: White Blood Cells)، ويمكن أن يُعاني المرء من

أعراض نقص كريات الدم البيضاء عند الرجال
توجد في الدم عدة أنواع من الخلايا، منها خلايا الدم البيضاء (بالإنجليزية: White Blood Cells)، ويمكن أن يُعاني المرء من مشاكل على مستوى هذه الخلايا، منها نقص الكريات البيضاء (بالإنجليزية: Leukopenia)، وفي الحقيقة إنّ لخلايا الدم البيضاء عدة أنواع، وهي: الخلايا القاعدية (بالإنجليزية: basophils)، والخلايا اللمفاوية (بالإنجليزية: lymphocytes)، والخلايا الوحيدة (بالإنجليزية: monocytes)، والخلايا المتعادلة (بالإنجليزية: neutrophils)، والخلايا الحمضية (بالإنجليزية: Eosinophil)، وعليه يمكن القول إنّ انخفاض عدد خلايا الدم البيضاء له خمسة أنواع، ويُحدّد النوعَ طبيعة الخلايا التي حدث فيها النقص، وأمّا بالنسبة للأعراض التي تظهر في مثل هذه الحالات فيأتي بيانها فيما يأتي:[1]
الأعراض العامة
في الحقيقة قد لا تظهر أية أعراض أو علامات تدل على انخفاض عدد خلايا الدم البيضاء في الجسم إلا إذا كان الانخفاض شديداً للغاية، ففي مثل هذه الحالات يُعاني المصاب من العدوى، ومن الأعراض والعلامات التي تدل على ذلك:[1]
- الحُمّى، وتتمثل بارتفاع درجة الحرارة عن 38 درجة مئوية.
- الشعور بالقشعريرة.
- التعرق.
أعراض نقص الخلايا المتعادلة
من الأعراض والعلامات التي تدل على نقص الخلايا المتعادلة نذكر ما يأتي:[2]
- ارتفاع درجة الحرارة بشكل بسيط.
- انتفاخ اللثة.
- قروح الفم.
- الالتهاب الرئوي الذي يُعرف أيضاً بذات الرئة.
أسباب نقص كريات الدم البيضاء
تتعدد الأسباب التي قد تكمن وراء المعاناة من نقص عدد خلايا الدم البيضاء عن المعدل الطبيعيّ، ومن هذه الأسباب نذكر ما يأتي:[3]
- بعض أنواع علاجات السرطان، مثل العلاج الإشعاعيّ.
- الأدوية المضادة للذهان (بالإنجليزية: anti-psychotic drugs).
- الادوية المستخدمة في علاج فرط نشاط الغدة الدرقية.
- بعض أنواع السرطانات، مثل: اللوكيميا.
- بعض أنواع العدوى، مثل: التهاب الكبد الوبائي وعدوى فيروس العوز المناعي البشري المُسبّب للإيدز.
- أمراض المناعة الذاتية، مثل: التهاب المفاصل الروماتيدي (بالإنجليزية: rheumatoid arthritis).
المراجع
- ^ أ ب "What Is Leukopenia?", www.healthline.com, Retrieved May 4, 2019. Edited.
- ↑ "Neutropenia Causes, Symptoms, Ranges, Levels, and Treatment", www.medicinenet.com, Retrieved May 4, 2019. Edited.
- ↑ "Low white blood cell count", www.nhs.uk, Retrieved May 4, 2019. Edited.
المقال السابق: لماذا تخرج رائحة كريهة من الفم
المقال التالي: كيفية معرفة وقت الإباضة عند المرأة
أعراض نقص كريات الدم البيضاء عند الرجال: رأيكم يهمنا
0.0 / 5
0 تقييم
